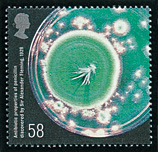

|
|
|
β受容体遮断薬の発明(1962)
ジェームス・ブラック(1924〜2010)
ノーベル賞1988年受賞。心電図,心臓
|
|
ペニシリンの発見(1928)
アレクサンダー・フレミング(1881〜1955)
ノーベル賞1945年受賞。シャーレの菌と溶菌
|
 |
|
 |
人工股関節全置換術の開発(1962)
ジョン・チャーンレイ(1911〜1982)
|
|
眼内レンズの開発(1949)
ハロルド・リドリー(1906〜2001)
|
 |
|
 |
マラリア感染の原因証明(1897)
ロナルド・ロス(1857〜1932)
ノーベル賞1902年受賞
|
|
CTスキャンの発明(1971)
ゴッドフリー・ハウンズフィールド(1919〜2004)
ノーベル賞1979年受賞
|
医学の進歩(6種)
イギリス(2010年)
|